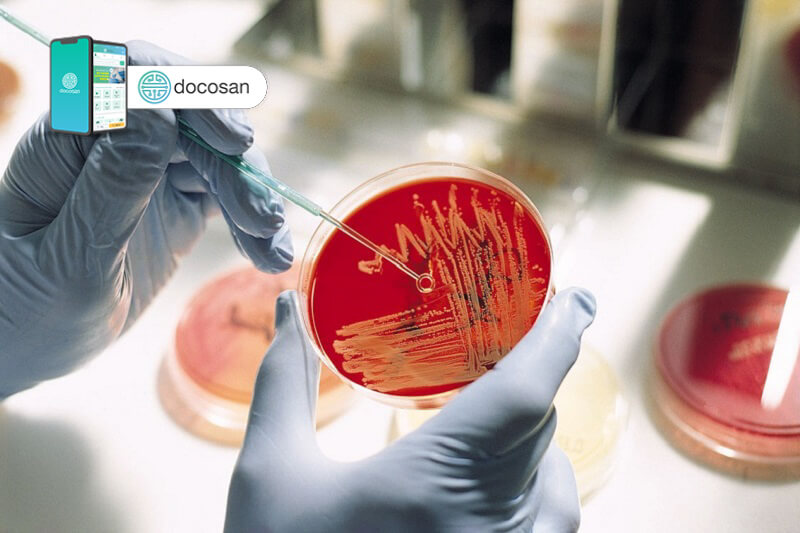

Phương pháp xét nghiệm AFB (xét nghiệm tìm trực khuẩn lao) để xem liệu bạn có bị bệnh về phổi như bệnh lao hay không. Ngoài việc cho thấy bệnh lao, test AFB cũng có thể cho thấy bạn có bị nhiễm một loại nhiễm trùng mycobacterium khác như bệnh phong hoặc bệnh giống lao có thể ảnh hưởng đến những người bị nhiễm HIV / AIDS hay không. Để hiểu rõ hơn về mục đích cũng như quy trình xét nghiệm, mời bạn đọc tham khảo nội dung dưới đây cùng Docosan.
Tóm tắt nội dung
Xét nghiệm AFB là gì?
Acid-fast bacillus (AFB) là một loại vi khuẩn gây bệnh lao và một số bệnh nhiễm trùng khác. Bệnh lao là một bệnh nhiễm trùng do vi khuẩn nghiêm trọng ảnh hưởng chủ yếu đến phổi. Nó cũng có thể ảnh hưởng đến các bộ phận khác của cơ thể, bao gồm não cột sống và thận. Bệnh lao lây từ người này sang người khác khi ho hoặc hắt hơi.
Lao có thể phát triển tiềm ẩn hoặc hoạt động. Nếu bạn mắc bệnh lao tiềm ẩn, bạn sẽ có vi khuẩn lao trong cơ thể nhưng sẽ không cảm thấy bị bệnh và không thể lây bệnh cho người khác. Nếu bạn mắc bệnh lao đang hoạt động, bạn sẽ có các triệu chứng của bệnh và có thể lây bệnh cho người khác.
Các xét nghiệm AFB thường được chỉ định cho những người có các triệu chứng của bệnh lao đang hoạt động. Các xét nghiệm tìm kiếm sự hiện diện của vi khuẩn AFB trong đờm của bạn. Đờm là chất nhầy đặc khi ho ra từ phổi. Nó khác với khạc nhổ hoặc nước bọt.

Có hai loại kiểm tra AFB chính:
Xét nghiệm phết tế bào AFB: Trong thử nghiệm này, mẫu của bạn được “bôi” trên một lam kính và được xem xét dưới kính hiển vi. Kết quả sẽ có sau 1–2 ngày. Những kết quả này có thể cho thấy khả năng bị nhiễm trùng hoặc có thể xảy ra, nhưng không thể đưa ra chẩn đoán xác định.
Nuôi cấy AFB: Trong thử nghiệm này, mẫu của bạn được đưa đến phòng thí nghiệm và đặt trong một môi trường đặc biệt để khuyến khích sự phát triển của vi khuẩn. Nuôi cấy AFB có thể khẳng định một cách tích cực chẩn đoán bệnh lao hoặc các bệnh nhiễm trùng khác. Nhưng phải mất 6-8 tuần để phát triển đủ vi khuẩn để phát hiện nhiễm trùng.
Mục đích xét nghiệm AFB
Các xét nghiệm AFB thường được sử dụng nhất để chẩn đoán nhiễm trùng lao (TB) đang hoạt động. Chúng cũng có thể được sử dụng để giúp chẩn đoán các loại nhiễm trùng AFB khác. Bao gồm các:
- Bệnh phong từng là nỗi sợ hãi nhưng giờ đây đã trở thành một căn bệnh hiếm gặp và dễ điều trị, ảnh hưởng đến thần kinh, mắt và da. Da thường đỏ và bong tróc, mất cảm giác.
- Một bệnh nhiễm trùng tương tự như bệnh lao, chủ yếu ảnh hưởng đến những người bị HIV / AIDS và những người khác có hệ miễn dịch suy yếu.
Các xét nghiệm AFB cũng có thể được sử dụng cho những người đã được chẩn đoán mắc bệnh lao. Các xét nghiệm có thể cho biết liệu phương pháp điều trị có hiệu quả hay không và liệu nhiễm trùng có thể lây lan cho người khác hay không.

Khi nào xét nghiệm AFB?
Bạn có thể cần xét nghiệm AFB nếu bạn có các triệu chứng của bệnh lao đang hoạt động. Bao gồm:
- Ho kéo dài từ ba tuần trở lên
- Ho ra máu và / hoặc có đờm
- Đau ngực
- Sốt
- Mệt mỏi
- Đổ mồ hôi đêm
- Giảm cân không giải thích được
Lao đang hoạt động có thể gây ra các triệu chứng ở các bộ phận khác của cơ thể ngoài phổi. Các triệu chứng khác nhau tùy thuộc vào phần nào của cơ thể bị ảnh hưởng. Vì vậy, bạn có thể cần kiểm tra nếu bạn:
- Đau lưng
- Có máu trong nước tiểu của bạn
- Đau đầu
- Đau khớp
- Yếu đuối
Bạn cũng có thể cần xét nghiệm nếu bạn có các yếu tố nguy cơ nhất định. Bạn có thể có nguy cơ mắc bệnh lao cao hơn nếu bạn:
Đã tiếp xúc gần với người được chẩn đoán mắc bệnh lao
Bị HIV hoặc một bệnh khác làm suy giảm hệ thống miễn dịch của bạn
Sống hoặc làm việc ở nơi có tỷ lệ nhiễm lao cao. Chúng bao gồm những nơi tạm trú cho người vô gia cư, viện dưỡng lão và nhà tù.

Điều gì xảy ra trong quá trình xét nghiệm AFB?
Bác sĩ sẽ cần một mẫu đờm của bạn để làm xét nghiệm AFB và nuôi cấy AFB. Hai bài kiểm tra thường được thực hiện cùng một lúc. Để lấy mẫu đờm:
- Bạn sẽ được yêu cầu ho sâu và khạc nhổ vào một hộp đựng vô trùng. Bạn sẽ cần làm điều này trong hai hoặc ba ngày liên tiếp. Điều này giúp đảm bảo rằng mẫu của bạn có đủ vi khuẩn để thử nghiệm.
- Nếu bạn gặp khó khăn khi ho ra đủ đờm, bác sĩ có thể yêu cầu bạn hít vào hơi sương (muối) vô trùng có thể giúp bạn ho sâu hơn.
- Nếu bạn vẫn không thể ho ra đủ đờm, bác sĩ có thể thực hiện một thủ thuật gọi là nội soi phế quản. Trong quy trình này, đầu tiên bạn sẽ được tiêm thuốc nên bạn sẽ không cảm thấy đau. Sau đó, một ống mỏng, sáng sẽ được đưa qua miệng hoặc mũi và vào đường thở của bạn. Có thể lấy mẫu bằng cách hút hoặc bằng chổi nhỏ.
Cần chuẩn bị gì khi xét nghiệm AFB?
Bạn không cần bất kỳ sự chuẩn bị đặc biệt nào khi xét nghiệm AFB.
Có bất kỳ rủi ro nào khi xét nghiệm AFB không?
Không có rủi ro khi cung cấp mẫu đờm bằng cách ho vào vật chứa. Nếu bạn nội soi phế quản, cổ họng của bạn có thể cảm thấy đau sau khi làm thủ thuật. Cũng có một ít nguy cơ nhiễm trùng và chảy máu tại nơi lấy mẫu.
Ý nghĩa kết quả xét nghiệm
Nếu kết quả của bạn trên phết tế bào AFB hoặc nuôi cấy âm tính, có thể bạn không bị lao hoạt động. Nhưng nó cũng có thể có nghĩa là không có đủ vi khuẩn trong mẫu để nhà cung cấp dịch vụ chăm sóc sức khỏe của bạn chẩn đoán.
Nếu phết tế bào AFB của bạn dương tính, điều đó có nghĩa là bạn có thể bị lao hoặc nhiễm trùng khác, nhưng cần phải cấy AFB để xác định chẩn đoán. Kết quả nuôi cấy có thể mất vài tuần, vì vậy bác sĩ có thể quyết định điều trị nhiễm trùng cho bạn trong thời gian chờ đợi.
Nếu kết quả cấy AFB của bạn dương tính, điều đó có nghĩa là bạn bị lao đang hoạt động hoặc một loại nhiễm trùng AFB khác. Việc nuôi cấy có thể xác định loại nhiễm trùng mà bạn mắc phải. Khi bạn đã được chẩn đoán, bác sĩ có thể yêu cầu một “bài kiểm tra tính nhạy cảm” trên mẫu đờm của bạn. Xét nghiệm độ nhạy cảm được sử dụng để giúp xác định loại kháng sinh nào sẽ cung cấp phương pháp điều trị hiệu quả nhất.
Nếu bạn có thắc mắc về kết quả của mình, hãy nói chuyện với nhà cung cấp dịch vụ chăm sóc sức khỏe của bạn.

Tạm kết
Nếu không được điều trị, bệnh lao có thể gây chết người. Nhưng hầu hết các trường hợp bệnh lao có thể được chữa khỏi nếu bạn dùng thuốc kháng sinh theo chỉ dẫn của bác sĩ. Điều trị bệnh lao mất nhiều thời gian hơn so với điều trị các loại bệnh nhiễm trùng do vi khuẩn khác. Sau một vài tuần dùng thuốc kháng sinh, bạn sẽ không còn lây nhiễm nữa, nhưng bạn vẫn sẽ bị lao.
Để chữa khỏi bệnh lao, bạn cần dùng thuốc kháng sinh từ 6 đến 9 tháng. Khoảng thời gian phụ thuộc vào sức khỏe tổng thể, tuổi tác và các yếu tố khác của bạn. Điều quan trọng là phải dùng thuốc kháng sinh trong thời gian mà bác sĩ chỉ định cho bạn, ngay cả khi bạn cảm thấy tốt hơn. Dừng lại sớm có thể khiến nhiễm trùng quay trở lại.
Bài viết được tham khảo từ bác sĩ và các nguồn tư liệu đáng tin cậy trong và ngoài nước. Tuy nhiên, Docosan Team khuyến khích bệnh nhân hãy tìm và đặt lịch hẹn với bác sĩ có chuyên môn để điều trị.
Nguồn tham khảo: medlineplus






